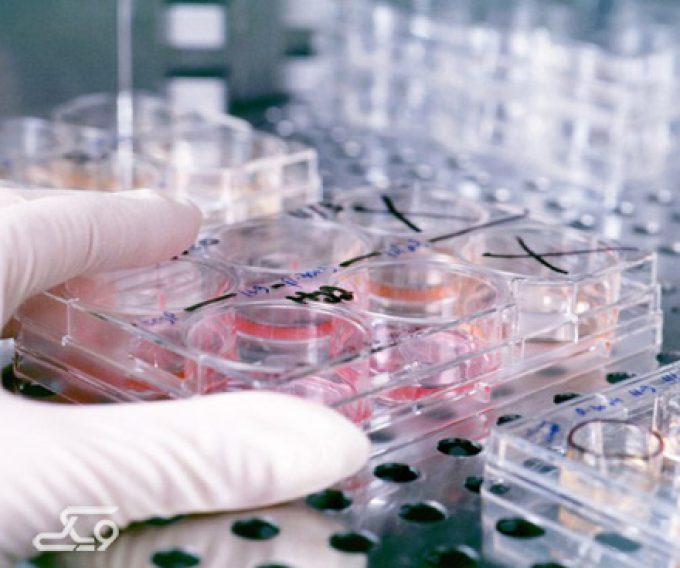
تجهیزات آزمایشگاهی و پزشکی سمنان آزما
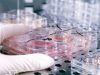
تجهیزات آزمایشگاهی و پزشکی سمنان آزما

فروشگاه تجهیزات آزمایشگاهی و پزشکی سمنان آزما در زمینه ی فروش تجهیزات و مواد آزمایشگاهی، تحقیقاتی، آموزشی، کلینیکی، صنعتی و دانشگاهی فعالیت می نماید.
این مجموعه تمام خدمات یا محصولات زیر را با کیفیت بالا عرضه می نماید:
- فروش مواد شیمیایی MERCK، Sigma، Fluka، BDH، Acros، ChemLab، Panreac، Scharla و ایرانی
- فروش و خدمات پس از فروش کلیه دستگاههای آزمایشگاهی خارجی و ایرانی
- تهیه و توزیع انواع محیط کشت میکروبی و سلولی MERCK ،Himedia ،Gibco ، و ایرانی
- پخش انواع کیت های تشخیص طبی و اعتیاد
- توزیع شیشه آلات و ظروف آزمایشگاهی از کمپانی های معتبر دنیا
- طراحی و ساخت شیشه آلات به صورت سفارشی
- فروش لوازم آزمایشگاهی و ظروف وسایل یک بار مصرف آزمایشگاهی
- مشاوره در زمینه راه اندازی آزمایشگاه و خرید تجهیزات و مواد آزمایشگاهی
- توزیع آب مقطر
بروشور فروشگاه سمنان آزما را در زیر دریافت نمایید: بروشور تجهیزات آزمایشگاهی و پزشکی سمنان آزما کلیک کنید.
برای برقراری ارتباط از طریق تلگرام و یا واتس آپ می توانید؛ از شماره زیر استفاده نمایید: